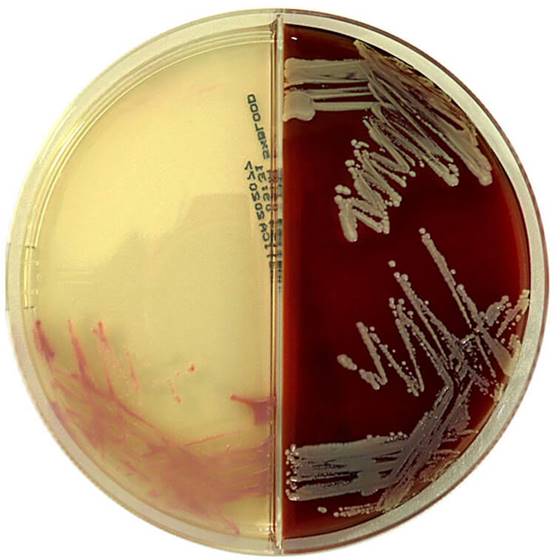

Über das Produkt
Chromogenes Medium zur Isolierung und Differenzierung von Methicillin-resistenten Staphylococcus aureus (MRSA).
Produkte
Mikrobiologie
CHROMagar™ - Fertigplatten
CHROMagar MRSA/Columbia-CNA+5% Schafblut
CHROMagar MRSA/Columbia-CNA+5% Schafblut
Chromogenes Medium zur Isolierung und Differenzierung von Methicillin-resistenten Staphylococcus aureus (MRSA).